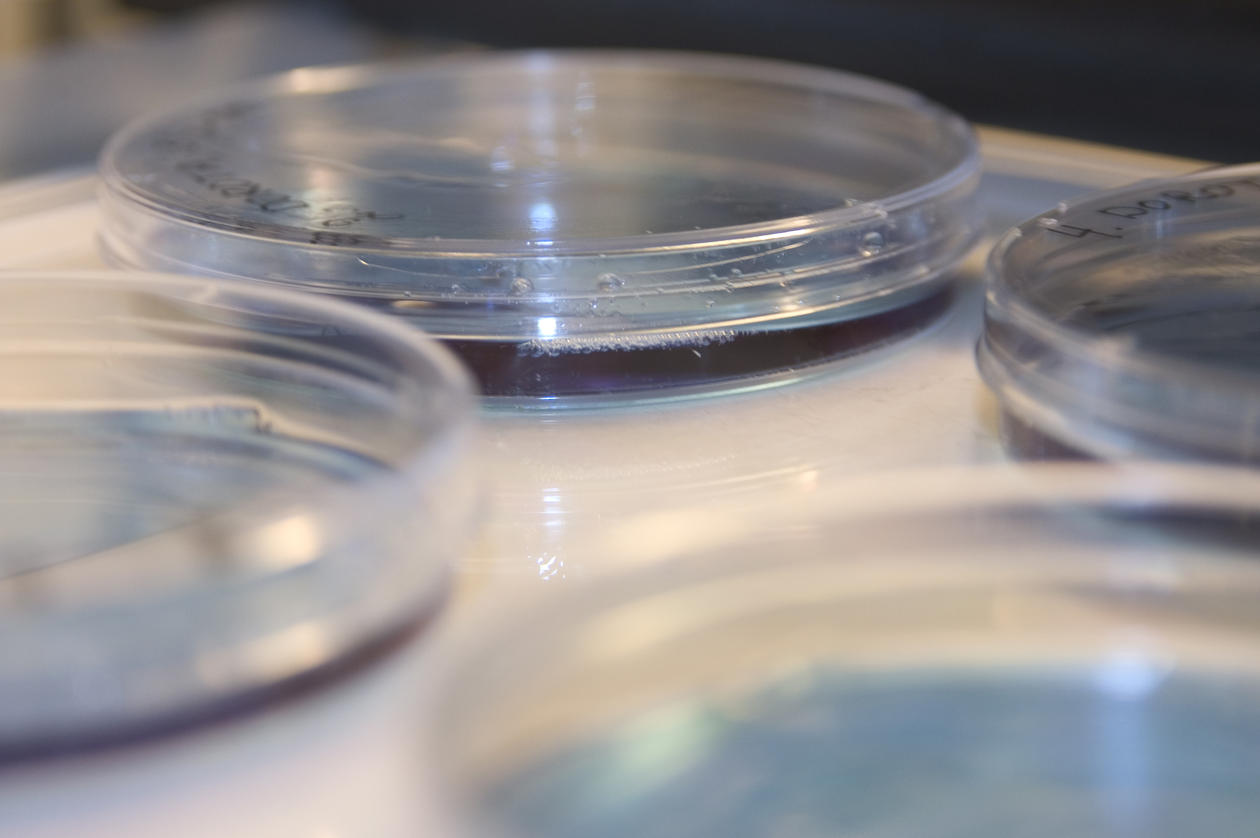

Call for Tenders
Call for Tenders for a study on the "Burden of Diseases potentially preventable by Maternal Immunization in sub-Saharan Africa"
Main content
Published: 10.08.2017
You will find here the publication details for a Call for Tenders for a study on the "Burden of Diseases potentially preventable by Maternal Immunization in sub-Saharan Africa". This Call for Tenders was prepared to respond a request from the European Parliament to launch a Pilot Project to "bridge the knowledge gaps for advancing maternal immunisation in low-resource settings". The pilot project is financed by the EP budget with € 600.000, and it includes both a desk study and a field study component. The deadline for receipt of tenders is 15/09/2017.